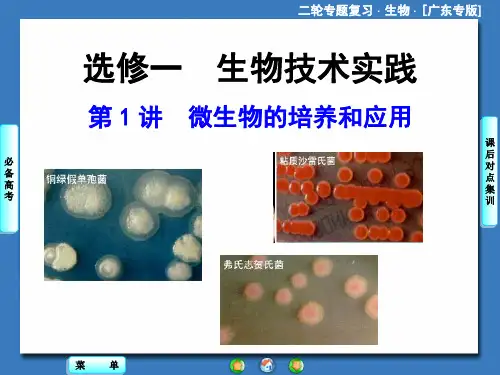

选修1第1讲 微生物的培养和利用
- 格式:doc
- 大小:61.50 KB
- 文档页数:5


课题:微生物的培养与应用教学目标:(一)知识与技能了解有关培养基的基础知识;掌握培养基的制备、高压蒸汽灭菌和平板划线法等基本操作技术(二)过程与方法分析实验思路的确定和形成的原因,分析实验流程,对比前面的实验设计,归纳共性,分析差异,增加印象(三)情感、态度与价值观形成勇于实践、严谨求实的科学态度和科学精神教学重点:无菌技术的操作教学难点:无菌技术的操作教学过程:(一)引入新课在传统发酵技术的应用中,都利用了微生物的发酵作用,其中的微生物来自于制作过程中的自然感染。
而在工业化生产中,为了提高发酵的质量,需要获得优良菌种,并保持发酵菌种的纯度。
这就要涉及到微生物的培养、分离、鉴别等基本技术。
现在我们开始学习微生物的培养和应用专题。
(二)进行新课1.基础知识1.1 培养基的种类包括固体培养基和液体培养基等。
〖思考1〗琼脂是从红藻中提取的多糖,在配制培养基中用作为凝固剂。
【补充】培养基的类型及其应用:C、H、O、N、P、S是构成细胞原生质的基本元素,约占原生质总量的97%以上。
【补充】碳源:如CO2、糖类、脂肪酸等有机物,构成微生物的结构物质和分泌物,并提供能量。
氮源:如N2、氨盐、硝酸盐、牛肉膏、蛋白胨等,主要用来合成蛋白质、核酸及含氮代谢物等。
含有C、H、O、N的化合物既可以作为碳源,又可以作为氮源,如氨基酸等。
1.3 培养基除满足微生物生长的pH 、特殊营养物质和氧气等要求。
【补充】生长因子:某些微生物正常生长代谢过程中必须从培养基中吸收的微量有机小分子,如某些氨基酸、碱基、维生素等。
〖思考3〗牛肉膏和蛋白胨主要为微生物提供糖、维生素和有机氮等营养物质。
〖思考4〗培养乳酸杆菌时需要添加维生素,培养霉菌时需要将培养基pH调节为酸性,培养细菌时需要将pH调节为中性或微碱性。
活动2:阅读“无菌技术”,讨论回答下列问题:1.4 获得纯净培养物的关键是防止外来杂菌的入侵。
1.5 无菌技术包括:(1)对实验操作空间、操作者的衣着和手进行清洁和消毒;(2)将培养器皿、接种用具和培养基等器具进行灭菌;(3)为避免周围微生物污染,实验操作应在酒精灯火焰附近旁进行;(4)避免已灭菌处理的材料用具与周围物品相接触。

人教版高级高中生物选修一专题二微生物的培养与应用知识点归纳文件排版存档编号:[UYTR-OUPT28-KBNTL98-UYNN208]专题二微生物的培养与应用课题一微生物的实验室培养·培养基:人们按照微生物对营养物质的不同需求,配制出供其生长繁殖的营养基质,是进行微生物培养的物质基础。
·培养基按照物理性质可分为液体培养基半固体培养基和固体培养基。
在液体培养基中加入凝固剂琼脂(是从红藻中提取的一种多糖,在配制培养基中用作凝固剂)后,制成琼脂固体培养基。
微生物在固体培养基表面生长,可以形成肉眼可见的菌落。
根据菌落的特征可以判断是哪一种菌。
液体培养基应用于工业或生活生产,固体培养基应用于微生物的分离和鉴定,半固体培养基则常用于观察微生物的运动及菌种保藏等。
·按照成分培养基可分为人工合成培养基和天然培养基。
合成培养基是用成分已知的化学物质配制而成,其中成分的种类比例明确,常用于微生物的分离鉴定。
天然培养基是用化学成分不明的天然物质配制而成,常用于实际工业生产。
·按照培养基的用途,可将培养基分为选择培养基和鉴定培养基。
选择培养基是指在培养基中加入某种化学物质,以抑制不需要的微生物生长,促进所需要的微生物的生长。
鉴别培养基是根据微生物的特点,在培养基中加入某种指示剂或化学药品配制而成的,用以鉴别不同类别的微生物。
·培养基的化学成分包括水、无机盐、碳源、氮源、生长因子等。
·碳源:能为微生物的代谢提供碳元素的物质。
如CO2、NaHCO3等无机碳源;糖类、石油、花生粉饼等有机碳源。
异养微生物只能利用有机碳源。
单质碳不能作为碳源。
·氮源:能为微生物的代谢提供氮元素的物质。
如N2、NH3、NO3-、NH4+(无机氮源)蛋白质、氨基酸、尿素、牛肉膏、蛋白胨(有机氮源)等。
只有固氮微生物才能利用N2。
·培养基还要满足微生物生长对pH、特殊营养物质以及氧气的要求。

高三一轮限时规范训练选修1第1讲微生物的培养和利用(时间:45分钟)A级基础演练1.(经典题)平板划线法和稀释涂布平板法是纯化微生物的两种常用方法,下列描述正确的是( )。
A.都要将菌液进行一系列的梯度稀释B.平板划线法是将不同稀释度的菌液通过接种环在固体培养基表面连续划线的操作C.稀释涂布平板法是将不同稀释度的菌液倒入液体培养基进行培养D.都会在培养基表面形成单个的菌落解析平板划线法不需要进行梯度稀释,稀释涂布平板法是将不同稀释度的菌液滴加到固体培养基的表面。
平板划线法和稀释涂布平板法都能在培养基表面形成单个菌落。
答案 D2.(2012·合肥四校质检)下列有关培养基和菌种鉴定的叙述不正确的是( )。
A.植物组织培养常用的是固体培养基B.可利用固体培养基上菌落的特征来判断和鉴别细菌的类型C.利用刚果红培养基上是否形成透明圈来筛选纤维素分解菌D.在无氮培养基中加入酚红指示剂鉴定尿素分解菌解析在只含有尿素作为氮源的培养基中加入酚红指示剂鉴定尿素分解菌。
答案 D3.下列是关于“检测土壤中细菌总数”实验操作的叙述,其中错误的是( )。
A.用蒸馏水配制牛肉膏蛋白胨培养基,经高温、高压灭菌后倒平板B.取104、105、106倍的土壤稀释液和无菌水各0.1 mL,分别涂布于各组平板上C.将实验组和对照组平板倒置,37 ℃恒温培养24~48 hD.确定对照组无菌后,选择菌落数在300以上的实验组平板进行计数解析在细菌计数时,为保证实验结果的准确性,一般选择菌落数在30~300的平板进行计数,求出平均数,再根据对应的稀释度计算出样品中的细菌数。
答案 D4.用稀释涂布平板法测定同一土壤样品中的细菌数,在对应稀释倍数为106的培养基中,得到以下几种统计结果,正确的是( )。
A.涂布了一个平板,统计的菌落数是230B.涂布了两个平板,统计的菌落数是215和260,取平均值238C.涂布了三个平板,统计的菌落数分别是21、212和256,取平均值163D.涂布了三个平板,统计的菌落数分别是210、240和250,取平均值233解析在设计实验时,一定要涂布至少3个平板作为重复组,才能增强实验的说服力与准确性,所以A、B不正确。




选修一生物技术实践
第1讲微生物的培养和利用
1.用平板划线法或稀释涂布平板法纯化大肠杆菌时( )
①能够用相同的培养基②都需要使用接种针实行接种③都需要在火焰旁实
行接种④都能够用来计数活菌
A.①②B.③④
C.①③D.②④
解析平板划线法或稀释涂布平板法都使用固体培养基,故①准确;平板划线法采用接种针实行操作,而稀释涂布平板法采用涂布器实行操作,故②错误;
纯化时,要实行无菌操作,需要在火焰旁接种,避免空气中的微生物混入培养基,故③准确;平板划线法一般用于分离而不是计数,故④错误。
答案 C
2.下列相关培养基和菌种鉴定的叙述不准确的是( ) A.植物组织培养常用的是固体培养基
B.可利用固体培养基上菌落的特征来判断和鉴别细菌的类型
C.利用刚果红培养基上是否形成透明圈来筛选纤维素分解菌
D.在无氮培养基中加入酚红指示剂鉴定尿素分解菌
解析在只含有尿素作为氮源的培养基中加入酚红指示剂鉴定尿素分解菌。
答案 D
3.通过实验测定土壤中的细菌数量,下列与此操作相关的叙述中,不.准确的是
( ) A.用蒸馏水配制牛肉膏蛋白胨培养基,经高温、高压灭菌后倒平板
B.取104、105倍的土壤稀释液0.1 mL,分别涂布于各组平板上
C.将培养皿倒置,37℃恒温培养24~48小时
D.选择菌落数在300个以上的培养皿实行计数
解析检测土壤中细菌总数,用蒸馏水配制牛肉膏蛋白胨培养基,经高温、高压灭菌后倒平板,取104、105、106倍的土壤稀释液和无菌水各0.1 mL,分别涂布于各组平板上,将实验组和对照组平板倒置,37℃恒温培养24~48小时,在确定对照组无菌后,选择菌落数在30~300的平板实行计数。
答案 D
4.用稀释涂布平板法测定同一土壤样品中的细菌数,在对应稀释倍数为106的培养基中,得到以下几种统计结果,准确的是( ) A.涂布了一个平板,统计的菌落数是230
B.涂布了两个平板,统计的菌落数是215和260,取平均值238
C.涂布了三个平板,统计的菌落数分别是21、212和256,取平均值163 D.涂布了三个平板,统计的菌落数分别是210、240和250,取平均值233 解析在设计实验时,一定要涂布至少3个平板作为重复组,才能增强实验的说服力与准确性,所以A、B不准确。
C项虽涂布了3个平板,但是,其中1个平板的计数结果与另两个相差太远,说明在操作过程中可能出现了错误,此时,不能简单地将3个平板的计数值用来求平均值。
答案 D
5.如表所示为分离分解尿素的细菌所用的培养基配方:
(1)该培养基含有微生物所需要的________类营养物质。
其中最主要的碳源是
葡萄糖,氮源是尿素。
(2)该培养基按物理性质划分是________培养基;按培养基的作用划分是选择
培养基,该培养基具有选择作用的原因是____、____________。
(3)在该培养基中,可通过检测pH的变化来判断尿素是否被分解,依据的原
理是________________________________________________________。
(4)若用该培养基来鉴定某种细菌是否能够分解尿素,可在培养基中加入
________指示剂,尿素被分解后指示剂变________色。
(5)某同学尝试使用罐头瓶在常温下制作果酒,开始时向消过毒的罐头瓶中加
入了新鲜的葡萄汁和酵母菌,添加酵母菌的原因是________,添加葡萄汁的目的是为酵母菌的生长发育提供_________________________。
答案(1)4
(2)固体该培养基中唯一的氮源是尿素,只有能分解尿素的微生物才能在该
培养基上生长和繁殖
(3)在细菌分解尿素的过程中,细菌合成的脲酶将尿素分解成氨,氨会使培养
基的pH升高
(4)酚红红
(5)酵母菌能分解葡萄糖形成酒精(或酵母菌实行无氧呼吸产生酒精) 所需的
各种营养物质(或碳源、氮源、水、无机盐和生长因子)
6.在日常生活中,一提到细菌、真菌及病毒这些微生物,人们往往首先想到它们的害处,其实,很多微生物对人类是有益的,它们与我们人类的关系非常密切,而且人类已经应用微生物造福于我们的生活。
请回答下列问题。
(1)从自然界获得纯种酿酒酵母菌的基本程序:配制培养基→接种→培养→观
察记录→纯化培养。
①采用平板划线法接种,开始接种时要灼烧接种环,目的是
________________________。
②若葡萄汁中含有醋酸菌,在葡萄酒发酵旺盛时,醋酸菌能否将酒精转变成
醋酸?________,原因是______________________________________。
(2)在腐乳的制作过程中,有多种微生物参与了豆腐的发酵,其中起主要作用
的是________。
产生的蛋白酶能将豆腐中的蛋白质分解成小分子的________,________可将脂肪水解为甘油和脂肪酸。
(3)利用纤维素解决能源问题的关键是高性能纤维素酶的获取。
科学家利用培
养基从土壤中选择出能分解纤维素的细菌,经过大量培养后可以从中提取纤维素酶。
土壤中富含各种微生物,将土壤浸出液接种到特定培养基上,可得到能分解纤维素的细菌,实验室中获取纯净菌的常用方法有________和________。
虽然各种培养基的具体配方不同,但一般都含有水、________。
解析(1)采用平板划线法接种,开始接种时要灼烧接种环,目的是灭菌;若葡萄汁中含有醋酸菌,在葡萄酒发酵旺盛时,醋酸菌不能将酒精转变成醋酸,原因是醋酸菌是好氧菌,葡萄酒发酵阶段的无氧条件抑制了醋酸菌的生长。
(2)在腐乳的制作过程中,有多种微生物参与了豆腐的发酵,其中起主要作用
的是毛霉。
产生的蛋白酶能将豆腐中的蛋白质分解成小分子的肽和氨基酸。
脂肪酶可将脂肪水解为甘油和脂肪酸。
答案(1)①灭菌②不能醋酸菌是好氧菌,葡萄酒发酵阶段的无氧条件抑制了醋酸菌的生长(2)毛霉肽和氨基酸脂肪酶(3)平板划线法稀释涂布平板法无机盐、碳源、氮源
7.纤维素分解菌能够产生纤维素酶分解纤维素。
回答下列问题:
(1)在筛选纤维素分解菌的过程中,通常用________染色法,这种方法能够通
过颜色反应直接对纤维素分解菌进行筛选。
甲同学在实验时得到了如图所示的结果,则纤维素分解菌位于()
A.③B.①②
C.②③D.①②③
(2)乙同学打算从牛胃中分离纤维素分解菌并计数,与分离醋酸菌相比,进行
培养时除了营养不同外,最主要的实验条件差别是______________________,该同学采用活菌计数法统计的菌落数目往往比活菌的实际数目________。
(3)丙同学在提取和分离纤维素酶的过程中,为了抵制外界酸和碱对酶活性的
影响,采取的措施是向提取液和分离液中添加________。
若探究纤维素酶活
性的最适温度,如何设置对照?___________________________________。
解析(1)刚果红与纤维素形成的红色复合物在纤维素被分解后将不再形成,则在培养基上出现以纤维素分解菌为中心的透明圈。
(2)牛胃是一个厌氧的环境,所以其中的纤维素分解菌与需氧的醋酸菌培养条件有所不同。
因是活菌计数法,所以部分死亡菌无法计数。
另外当两个或多个细菌连在一起时平板上只观察到一个菌落,所以偏小。
(3)探究最适温度可设置一系列的温度梯度相互对照,其他无关变量要适宜。
答案(1)刚果红A(2)保证无氧环境小(低)
(3)缓冲溶液不同的温度梯度之间相互对照。